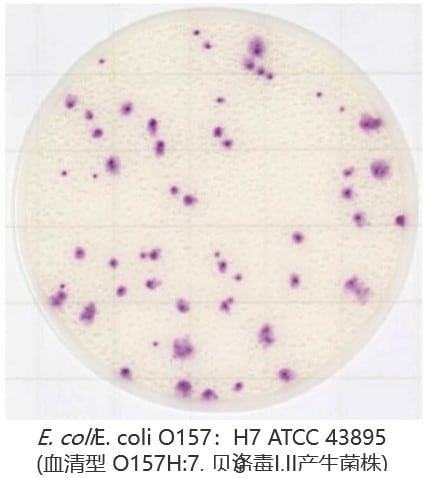

Easy Plate 可作为传统培养法的替代方案,节省时间和人力。其操作简单,无需制备培养基或高压灭菌操作,即开即用,打开包装后可直接将样液滴入培养基,且Easy Plate(体积约为培养皿的1/20)具有可堆叠放置的特点,减少空间的同时也能减少使用后的废弃量。
Easy Plate 可作为传统培养法的替代方案,节省时间和人力。其操作简单,无需制备培养基或高压灭菌操作,即开即用,打开包装后可直接将样液滴入培养基,且Easy Plate(体积约为培养皿的1/20)具有可堆叠放置的特点,减少空间的同时也能减少使用后的废弃量。

Easy Plate EC EC已经取得AOAC PTM认证,用于检测大肠杆菌和大肠菌群,其包含两种显色底物使大肠杆菌菌落呈现出蓝紫色至靛蓝色,非大肠杆菌的大肠菌群菌落呈现出粉红色至紫红色。使您在24±1小时内轻松识别大肠干群或大肠菌群,菌落的独特颜色有助于克服食品和液体中的常见干扰,更易于识别和计数。Easy Plate EC每包100片测试片,装在4个独立的包装袋中,每袋25片。2-8℃未开封的条件下储存时保质期为18个月。

食品样品检查中与各种标准琼脂培养基对比一致性较高※

※大日本印刷株式会社研究所得
取得AOAC PTM认证(License No.031601)
几乎所有的大肠杆菌都会产生β-葡萄糖醛酸酶,但E. coli O157:H7具有不产生β-葡萄糖醛酸酶的特性,显色与大肠菌群相同(红紫色)。
部分非加热的食物和乳制品中含有的酶会使培养基全面显色反应,影响菌落判定时可以通过适当稀释来提高菌落的可识别性。
| Escherichia coli (NBRC 15034) |
Escherichia coli (NBRC 13500) |
Escherichia coli (NBRC 102203) |
![]() |
![]() |
![]() |
| Klebsiella pneumoniae (ATCC 13883) |
Enterobacter cloacae (ATCC 222) |
Citrobacter freundii (NBRC 12681) |
![]() |
![]() |
![]() |
| Raw ground chiken | Raw salmon | Raw shrimp |
![]() |
![]() |
![]() |
| Roast beef + E. coli | Omelet + E. coli | Icecream + E. coli |
![]() |
![]() |
![]() |
| 产品名称 | Easy Plate EC |
|---|---|
| 产品编号 | 61975 |
| 微生物检测项目 | 大肠杆菌&大肠菌群 |
| 培养时间 | 24 ± 1 小时 |
| 培养温度 | 35 ± 1℃ |
| 未开封保存条件 | 2 - 8℃ |
| 开封后保存条件 | 请将包装袋的开口端折叠至少2次并用胶带固定,存放于冰箱(2 – 8℃)中并在3个月内使用 |
| 有效期 | 生产日起18个月 |
| 认证 | AOAC RI PTM 认证, MicroVal 认证, NordVal 认证 |
| 产品规格 | 100 片 (25片 x 4包/盒)![]() |